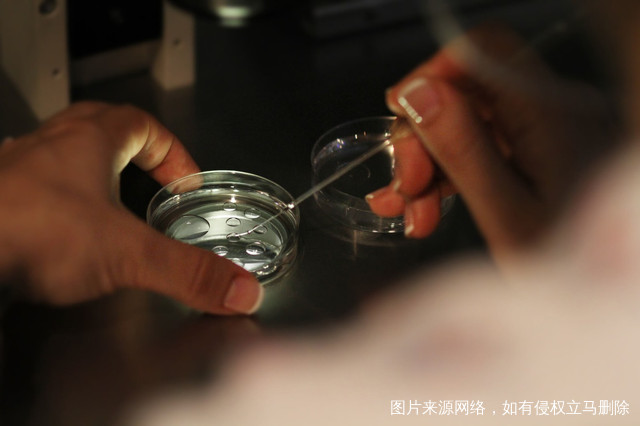

卵巢早衰闭经能治好吗?卵巢早衰闭经怎么调理?发布:2020-02-17 09:48:06
卵巢早衰在最近几年似乎成为很多女性非常关注的一种情况,一旦女性出现这些情况的话,就会对自身产生影响,那么如果女性使这些卵巢早衰引起的闭经这种现象的话,她们最关注的就是卵巢早衰闭经能治好吗?毕竟在这些实际诊疗的过程当中,大家也不知道会有什么样的情况,所以一旦我们遇到这些问题的时候,一定要用平常心来看待。
卵巢早衰闭经能治好吗?
很多女性在面对闭经这件事情的时候,自己内心都是非常紧张的,在这里要告诉大家的就是现代医学还是非常发达的,一旦出现了闭经这种情况,我们可以到医院进行治疗,不能说每一个患者都能够治好,但是临床上大部分的患者都是可以治好的,当然我们也要明白为什么会出现闭经这种现象,如果是生理性的话,其实大家根本就没有必要治疗。
卵巢早衰闭经怎么治疗?
在平常的时候,建议大家最好不要选择一些劣质的染发剂或者是增白的化妆品,因为这些东西里面都含有各种不同的化合物,同时我们在选择洗洁剂的时候,最好不要选择那些带有氢类替代物的东西,因为你如果我们一旦选择了有这些成分的东西的话,就会对自身产生影响,通过这些东西完全能够让化学物质进入到自己的皮肤粘膜,这会造成女性的卵巢功能,受到更多损伤,会影响到女性的孕育功能。
均衡营养是非常重要的,在平常的时候大家一定要注意,最好不要挑食,也不要节食,这样的话可能会造成营养不良,我们要避免会对女性的免疫能力产生影响,在短时间内要通过各种不同的方式来迅速提升女性的免疫能力,同时我们也要不断加强锻炼,而且要多吃一些动物的肝脏,这样有利于激素的合成维生素是非常重要的一种营养品,大家在平常的时候可以多吃一些含有蛋白质或者是维生素较为丰富的食品。少吃生冷和辛辣刺激性的东西。
焕发卵巢生机,修复激活卵泡

分阶段、分步骤
最大程度提高卵子的质与量



卵巢问题的姐妹好孕日记
试管好孕日记










































